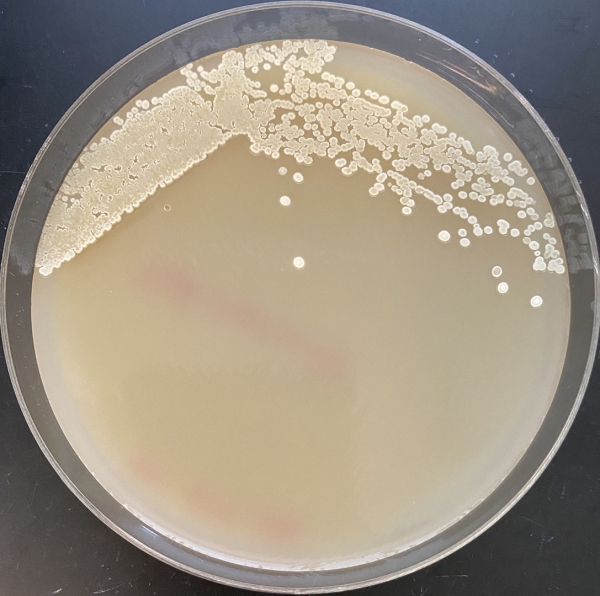

Scientists find new route in bacteria to decarbonize industry. The discovery could reduce greenhouse gas emissions from the manufacturing of fuels, drugs, and chemicals.
A research team led by Lawrence Berkeley National Laboratory (Berkeley Lab) and UC Berkeley has engineered bacteria to produce new-to-nature carbon products that could provide a powerful route to sustainable biochemicals.
The advance – which was recently announced in the journal Nature – uses bacteria to combine natural enzymatic reactions with a new-to-nature reaction called the “carbene transfer reaction.” This work could also one day help reduce industrial emissions because it offers sustainable alternatives to chemical manufacturing processes that typically rely on fossil fuels.
“What we showed in this paper is that we can synthesize everything in this reaction – from natural enzymes to carbenes – inside the bacterial cell. All you need to add is sugar and the cells do the rest,” said Jay Keasling, a principal investigator of the study and CEO of the Department of Energy’s Joint BioEnergy Institute (JBEI).
Read more at DOE/Lawrence Berkeley National Laboratory
Image: During experiments at DOE’s Joint BioEnergy Institute, researchers observed an engineered strain of the bacteria Streptomyces as it produced cyclopropanes, high-energy molecules that could potentially be used in the sustainable production of novel bioactive compounds and advanced biofuels. (Image courtesy of Jing Huang)